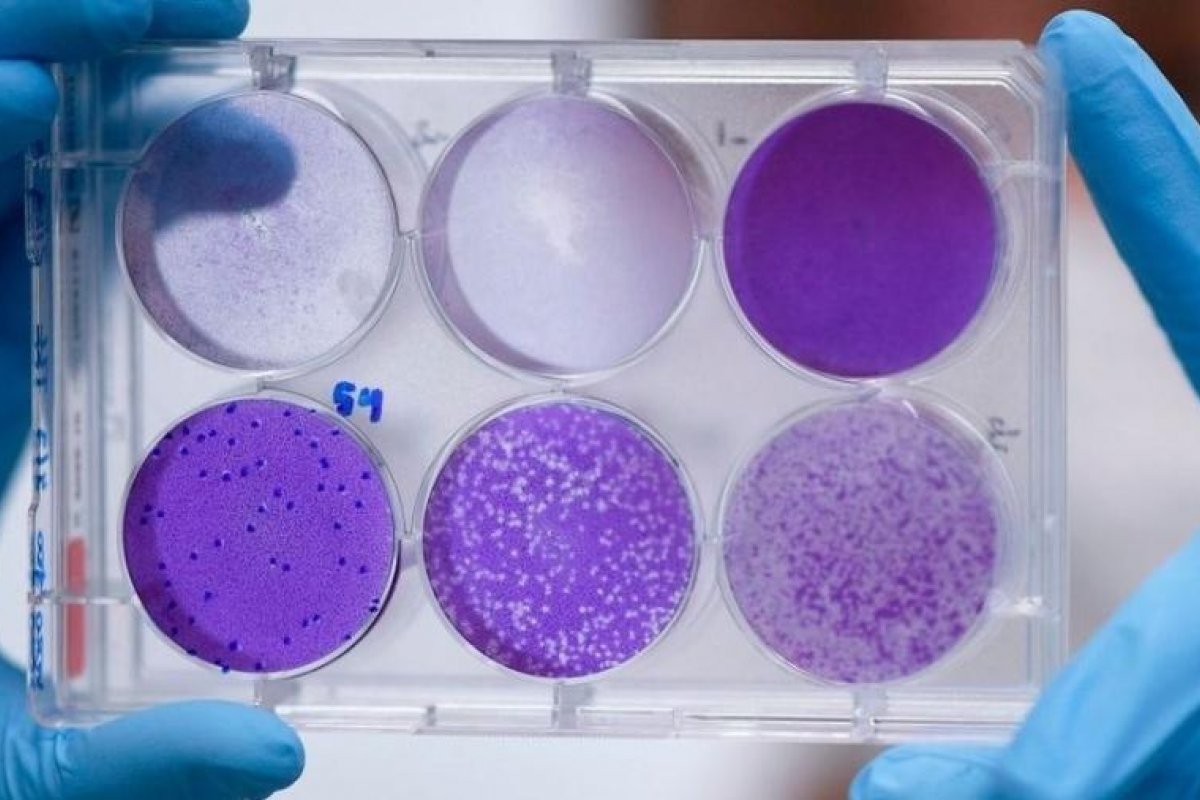
Coronavírus se transformou em 30 cepas distintas, revela estudo na China

Coronavírus se transformou em 30 cepas distintas, revela estudo na China
Tal mudança pode explicar os casos mais agressivos
Foto: Reprodução/ Getty Images
Um estudo feito por cientistas da Universidade de Zhejiang apontam que o SARS-CoV-2, causador da Covid-19, já deu origem a mais de 30 cepas diferentes. Elas são alterações morfológicas, uma espécie de evolução do vírus inicial.
De acordo com o jornal South China Morning Post, as cepas possuem níveis de carga viral diferentes, tornando-as mais perigosas. Uma dessas variações pode carregar até 270 vezes mais carga viral. Isso significa que uma pessoa infectada produz 270 vezes a quantidade de vírus que uma pessoa contaminada na atualidade.
"O Sars-CoV-2 adquiriu mutações capazes de alterar substancialmente sua patogenicidade", disse o epidemiologista Li Lanjuan, responsável pelo estudo. Em março, antes de a OMS declarar o estado de pandemia, cientistas chineses já haviam identificado pelo menos duas cepas do coronavírus. A multiplicação de diferentes cepas pode explicar porque alguns casos de covid-19 são mais agressivos. Além disso, também fica mais difícil combater a infecção.
No Brasil, o genoma do vírus já foi sequenciado algumas vezes. O primeiro realizado na Amazônia revelou que o coronavírus já tem 11 mutações em relação ao que foi sequenciado em São Paulo, em fevereiro deste ano. Isso aponta para a circulação de linhagens diferentes do vírus no país.
A diferença encontrada entre os vírus dentro do Brasil é maior do que as do vírus original de Wuhan, na China, onde foram registrados os primeiros casos da covid-19. Ao todo, foram nove mutações diferentes achadas no coronavírus da Amazônia em comparação ao chinês. A pesquisa foi feita na Fiocruz (Fundação Oswaldo Cruz) Amazônia, em Manaus, e coordenada pelo cientista na área de virologia e biologia molecular, Felipe Naveca.
“A gente não tem ainda como saber se essas mutações da China para cá já são alguma coisa que terá impacto do ponto de vista clínico. A priori não tem nada que a gente possa dizer que a mutação aqui está relacionada a um aumento de virulência desse vírus”, afirmou.


